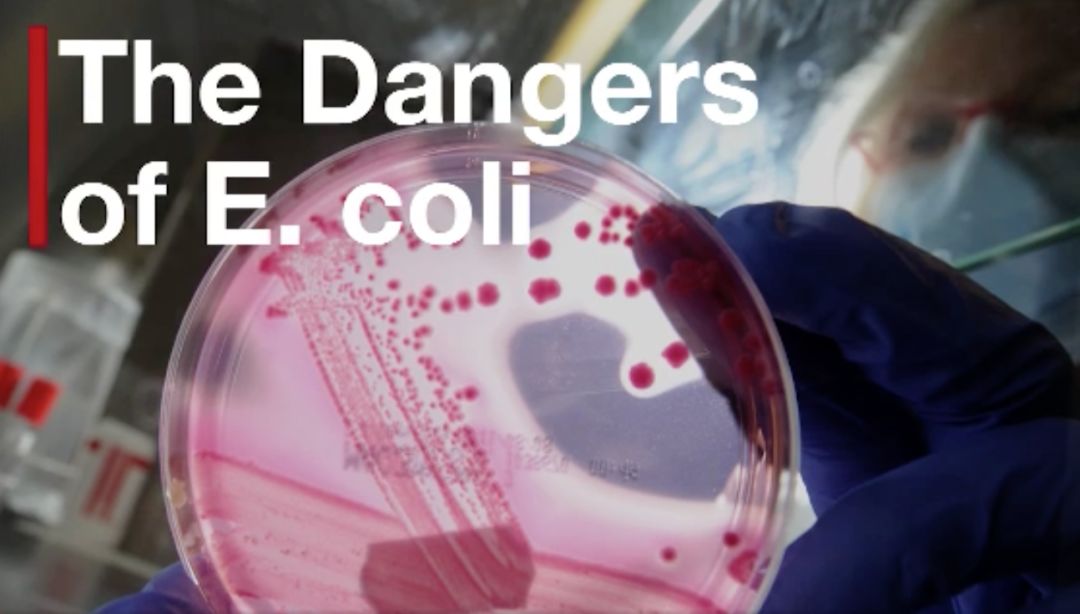

美国最近可谓是“祸不单行”,先是遭遇十年一遇寒冬,接着湾区发生午夜地震,现在连吃个菜都出现问题…..近日,北美突发大面积大肠杆菌感染事件,截至目前导致2人死亡,病因竟是吃了下面这种生菜。

北美爆发大肠杆菌感染
据CNN等媒体报道,美国和加拿大爆发同一株型大肠杆菌(E.coli)感染的病例。美国疾病控制和预防中心在12月28日发表的声明:
仅11月15日至12月8日期间
美国13个州已出现17人感染
加州出现1例死亡案例
全美5人正在接受住院治疗
2人出现溶血性尿毒症综合症
1人出现肾衰竭

加拿大比美国疫情更加严重,目前已有41人感染(年龄3-85岁),1人死亡。加拿大公共卫生当局称,已确定感染源头是零售店和餐馆出售的长叶生菜(romaine lettuce)。
专家建议:生菜不要吃
这次严重的疫情爆发的罪魁祸首就是大肠杆菌,虽然FDA仍在调查传染源,但食品专家建议近期还是避免吃生菜。
主要病因:
大肠杆菌(O157∶H7)感染

疫情覆盖13个州:
加利福尼亚州(3例)、康涅狄格州(2例)、伊利诺斯州(1例)、印第安纳州(1例)、密歇根州(1例)、内布拉斯加州(1例)、新罕布什尔州(2例)、纽约州(1例)、俄亥俄州(1例)、宾夕法尼亚州(1例)、弗吉尼亚州(1例)、佛蒙特州(1例)、华盛顿州(1例)

死伤感染人数:
59人感染,其中2人死亡
华人该怎么办?
美国食品药品监督管理局(FDA)和疾病控制和预防中心(CDC)仍在调查,未确定传染源,未建议民众避免吃生菜或其他特定的食物。FDA的网站也没有任何召回感染生菜的列表。
加拿大卫生当局建议,东部省份市民不要吃长叶生菜(romaine lettuce),考虑其他种类的生菜和蔬菜沙拉,等待进一步通知。加拿大甚至禁止一些商店出售这款生菜。

消费者报告(CR)食品安全专家建议,在感染源确定前,消费者应该停止食用生菜,尤其是幼童、老年人、免疫系统弱或患有免疫系统疾病(如癌症或糖尿病)人群,而卫生部门应将相关问题产品下架。
城市君建议华人朋友,在接到卫生部门正式通知前,先不要购买或食用生菜,包括冰箱现存的,也不要食用含生菜的沙拉。
大肠杆菌到底有多可怕
大肠杆菌几乎到处都是,它们通常是无害的消化道居民,生长在健康人类和动物的肠道内的绝大多数菌种都是无害的,但O157∶H7这一菌种却会产生强烈的毒素,并引发严重的疾病。
感染症状:
胃痉挛、血性腹泻、腹痛、呕吐、极度疲劳、减少排尿、脸色苍白,有些人可能有轻微发烧。约5-10%感染人群出现溶血性尿毒症综合征(HUS),导致肾衰竭,甚至引起死亡。

潜伏期:
在进食污染食物后1至3天开始,但可能在10天后发生
传播途径:
饮用受污染的水、未消毒的奶类、果汁或进食未熟透的食物(尤其是牛肉)、受污染的芝士、乳酪、蔬菜。此外,个人卫生欠佳,进食受粪便污染的食物,或人与人之间传播,如携带细菌的人在使用洗手间时不洗手。

如何预防:
保持厨房及厨具餐具的卫生清洁;
勤洗手,尤其在进食或加工食物前,用肥皂和清水洗净双手;
食物加工前,应清洗彻底;
尽量避免进食未熟透的食物,尤其是肉类食品,食物加热至摄氏75度及以上,可消灭大肠杆菌O157∶H7;
生熟食物分开处理,避免交叉污染;
熟食应尽快食用,不要徒手处理熟食,最好戴上手套;
定期清洁冰箱。

生菜来源:
这次出事的生菜是由美国最大食品供应公司——康帕斯(Campass group)供应,他们主要为全美公司的咖啡馆、医院和学校食堂提供食材。

康帕斯公司表明,生菜在种植或加工过程均可能被污染,现在任何生菜,即使带包装的,都可能被污染。生菜有长达五周的保质期,所以你几周前购买的生菜也可能被污染。
不吃生菜,还有这些高营养蔬菜可以选择
美国超市的蔬菜选择性真的少的可怜,如今生菜都吃不了了,其实还有很懂华人很少吃,但营养价值很高的蔬菜可以选择!
朝鲜蓟(Artichoke)

去超市看到这个长得像仙人球的东西总是会绕道,可不知它营养价值特别高!她又被称为是法国百合,在欧洲被誉为“蔬菜之王”,属于高档蔬菜。
美国超市卖的朝鲜蓟基本都产自加州,3-5月是吃朝鲜蓟最好的时节。最好挑选深绿色、中等个头、比较沉的,轻轻捏一下能感受到里面汁水在往外冒,就说明很新鲜。朝鲜蓟热量低脂肪少,有丰富的膳食纤维,富含维生素BC和矿物元素,还有降低血脂胆固醇和抗氧化的作用。
韭葱(Leek)
嘿!少骗人,这不就是大葱么!其实他是大葱失散在国外多年的孪生兄弟,叫韭葱。欧洲在古希腊、古罗马时已有栽培,直到20世纪30年代才传入中国,它是介于青蒜苗和大葱之间的植物,味道也相似。
韭葱中含有大量的的维生素C,有舒张小血管,促进血液循环的作用,有助于防止血压升高所致的头晕,使大脑保持灵活和预防老年痴呆的作用。而且经常吃韭葱的人,即便脂多体胖,但胆固醇并不增高,而且体质强壮。

很多人不知道,这个韭葱出了可以食用之外,还有观赏价值,她的花为淡粉色的伞球状,十分好看。你要是不知道怎么做菜,不妨买回去装饰一下花园也不错。
抱子甘蓝(Brussels Sprouts)
这是我们常在超市看到的迷你包菜,在美国超市挑选抱子甘蓝最好选小的,球体越小越嫩。抱子甘蓝的小叶球蛋白质的含量很高,居甘蓝类蔬菜之首,维生素C和微量元素硒的含量也较高。

羽衣甘蓝(Kale)
这名字听起来就很文艺,她最近在美国火到不行,一是因为它无敌的营养价值(含有大量的维生素A、C、B2,钙、铁、钾等矿物质含量很高。),而且超低热量的她,成为当红的明星减肥食品,越吃越瘦,成为减肥妹子们的福音,榨成汁、烤成零食、凉拌下菜、总之怎么样她都火!


欧芹(Parsley)
外形很像芹菜叶子,跟香菜也类似,在洗菜里面的地位相当于中餐中的香菜。刚去美国很容易把两者弄混,拿起来闻一下,气味的差别还是很明显的。

欧芹产于地中海地区,公元前3世纪欧芹就在罗马人的厨房里出现,它在古埃及和及希腊人眼里都代表胜利,士兵打仗胜利后悔戴上欧芹编织成的花冠。医学上古埃及人把它视为珍宝,认为欧芹可以治疗泌尿疾病。
罗勒(Basil)
罗勒虽然家里很少买,但是在餐厅吃饭并不少见,尤其在越南米粉中出镜率超高。罗勒的香气浓烈,可能很多华人都觉得刺鼻怪异难以接受。

甜菜(Beet)
甜菜的根部和叶子都能吃,甜菜在国内并不少见,只是在北方多用于制糖,很少直接食用。

欧防风(Parsnip)
长得像“沧桑版”的白萝卜,表皮没有白萝卜光滑,褶皱较多。欧防风营养丰富,营养元素与马铃薯类似,碳水化合物含量高。多吃欧防风可以补充钾元素,这在蔬菜中是很少见的。

大黄(Rhubarb)
大黄的样子其实是红色的芹菜,外形与名字千差万别。大黄是多种蓼科大黄属的多年生植物的合称,也是中药材的名称。在中国,大黄主要作药用,在北美,大黄多用于甜点,因其味道酸,西式做法多用于制成果酱拌酸奶,或者作为水果挞的馅料。

冬南瓜(Butternut Squash)
美国的南瓜都是加大号的,而且形状奇特。最特别的是一种长得像巨型梨子的南瓜,上面细长,底部圆圆的,这种南瓜维生素A含量特别高,多吃对皮肤好,还能促进骨骼健康。

关于此次带有大肠杆菌的生菜到底供应到了哪些超市,此次疫情更多细节城市君将持续关注更新!
本平台原创内容,未经授权,谢绝公众号商业转载
